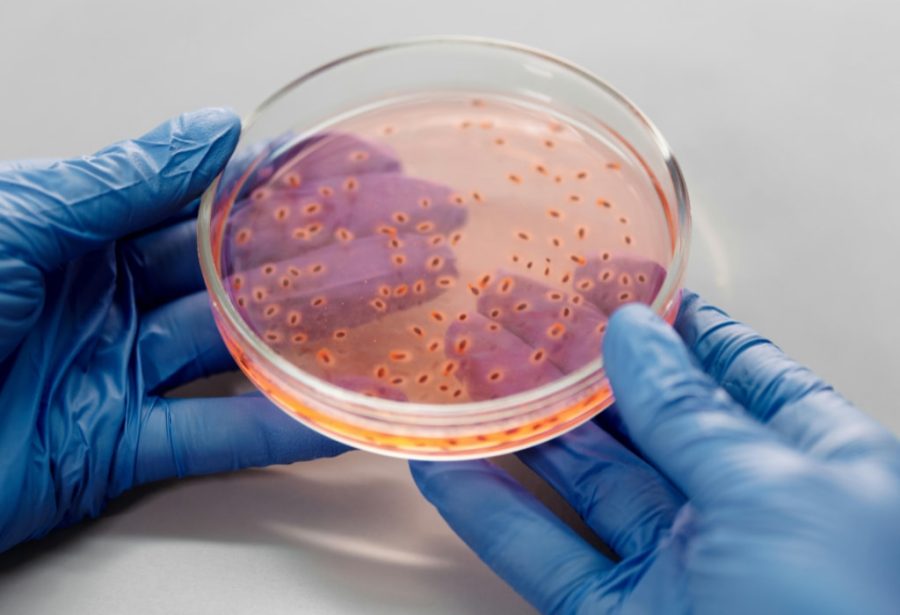
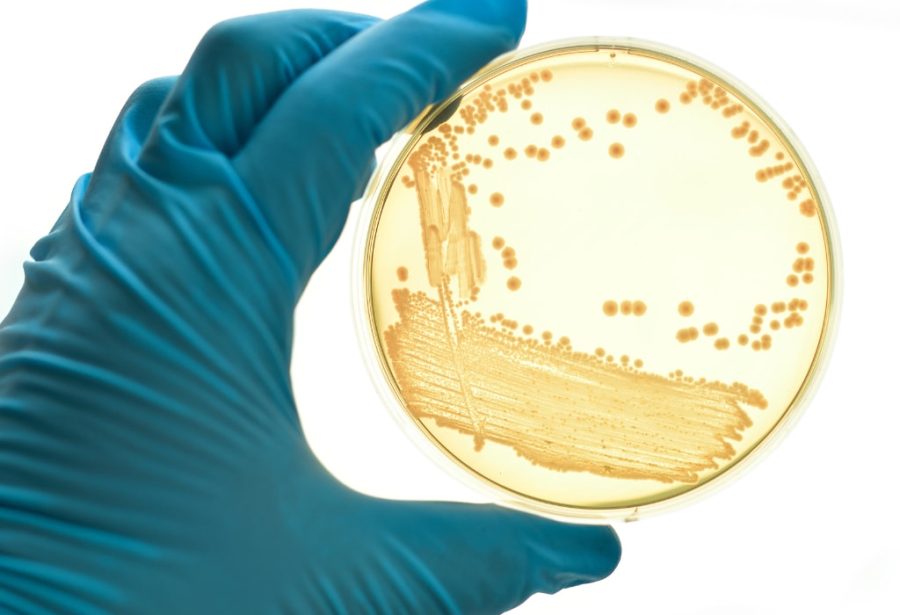
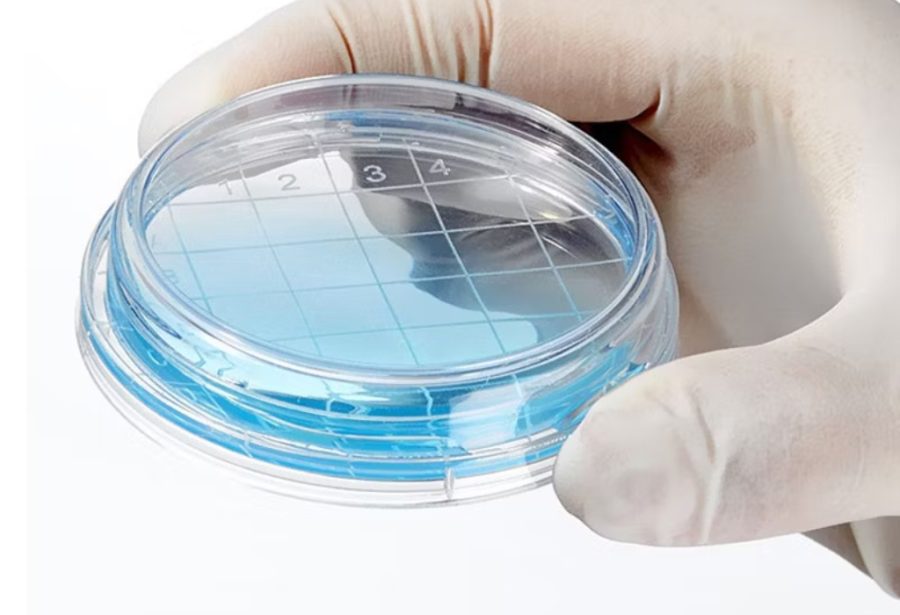
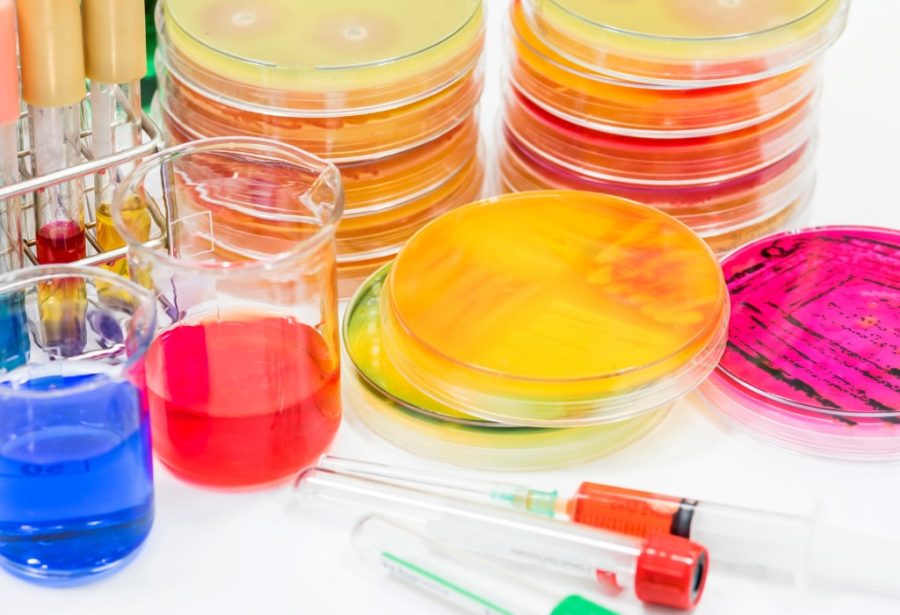

Una marca registrada de soluciones microbiológicas desarrollada por D Q Microbiología.
Placas 60x15 mm
Placas listas para usar para el análisis microbiológico mediante filtración por membrana. Están formuladas para detectar diferentes tipos de bacterias en condiciones específicas.
📂 Productos disponibles
- Agar m-Green
- Agar TGE
- Agar ENDO
- Agar Cetrimida
- Agar Suero de Naranja
- Agar PRY
- Agar Tergitol 7
- Agar Cromogénico
- Agar MRS
- Agar PCA (sin glucosa)
📦 Presentación: caja con 50 placas

Ampolletas (3ml)
Medios líquidos listos para su uso, recomendados para procesos de enriquecimiento o dilución.
Ideales para pruebas preliminares y crecimiento selectivo.
📂 Productos disponibles
- Caldo m-Green
- Caldo Caldo TGE
- Caldo ENDO
- Caldo Cetrimida
- Caldo m-FC
- Caldo Suero de Naranja
- Caldo PRY
- Caldo Cetrimida con ácido nalidíxico
- Caldo Métodos Estándar
- Caldo Cromogénico
📦 Presentación: caja con 50 ampolletas
Placas 90x15 mm
Formuladas para el monitoreo ambiental y de superficies en áreas controladas.
📂 Productos disponibles
- Agar Rosa de Bengala
- Agar Mac Conkey
- Agar Papa Dextrosa
- Agar Bilis Rojo Violeta (Glucosa)
- Agar Métodos Estándar
📦 Presentación: 10 placas por caja
Placas de Contacto
Diseñadas para control microbiológico de superficies en ambientes industriales y hospitalarios.
Se utilizan presionando la superficie de la placa sobre la zona a monitorear. Especiales para salas limpias, producción estéril y farmacéutica.
📂 Productos disponibles
- MCPI-02: Agar Soya Tripticaseina
- MCPI-03: Agar Dextrosa Sabouraud
- MCPI-04: Agar Soya Tripticaseina
- MCPI-05: Agar Soya Tripticaseina
- MCPI-06: Agar Dextrosa Saouraud
- MCPI-07: Agar Soya Tripticaseina con Lecitina y Polisorbato 80
- MCPI-08: Agar Bilis Rojo Violeta con Glucosa
- MCPI-09: Agar Bilis Rojo Violeta con Lactosa
- MCPI-10: Agar Dextrosa Saboraud con Lecitina y Polisorbato 80,
📦 Presentación: Caja con 10 placas

Membranas y filtros
Consumibles y dispositivos auxiliares para métodos de filtración microbiológica.
Compatibles con medios de cultivo Microculture-Test®, permiten la filtración directa de muestras líquidas para recuento bacteriano.
📂 Productos disponibles
- Membrana blanca 0.45 µm, 47 mm
- Membrana negra 0.80 µm, 47 mm
- Unidad de filtración de polisulfona con vaso de 300 ml
- Unidad esterilizadora de microondas
📦 Presentación: según producto
Kits y medios auxiliares
Formulaciones específicas para microorganismos particulares o aplicaciones especializadas.
Desarrollados para bacterias exigentes o ensayos que requieren mayor selectividad.
📂 Productos disponibles
- Kit Guayacol (medio YSG, COSMO BIO)
- Medio Slanetz Bartley
- Agar Triptosa Sulfito Cicloserina
- Agar Cetrimida con ácido nalidíxico
Otros socios comerciales





























